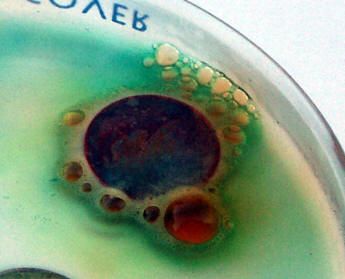

|
|

|
|
DrBenWay, 77 anni spritzino di PADOVA CHE FACCIO? Mando a cagare sedicenti intellettuali padovani. Sono middle [ SONO OFFLINE ] [ PROFILONE ] [ SCRIVIMI ] STO LEGGENDO "Furore" J. Steinbeck "Il centenario che saltò dalla finestra e scomparve" Jonas Jonasson "Pao pao" P.V. Tondelli "54" Wu Ming "La piramide di fango" A. Camilleri. HO VISTO Stanze dalbergo così tristi che neanche Paolo Conte. Ministri con la pancia piena discettare sul bisogno di mettere a dieta chi mangia una volta al giorno. Dipendenti talmente servi da firmare documenti a favore del licenziamento di colleghi. Datori di lavoro privi di ogni pudore capaci di ritenere un atto dovuto il lavoro gratuito dei dipendenti. STO ASCOLTANDO Devo fare outing: odio i tabagisti. nellattuale rapporto numerico rompono i coglioni molto, molto più degli eroinomani. ABBIGLIAMENTO del GIORNO Paillettes, boa di struzzo e bottiglione da due litri. ORA VORREI TANTO... Scanalare onomatopee. Fresare metafore. Grattuggiare i calli. Un nastro adesivo abbastanza forte da tenere assieme questa cazzo di vita. La rivoluzione francese in Italia. Ghigliottina compresa. STO STUDIANDO... Non lo so. Per quello studio. OGGI IL MIO UMORE E'... "...Guarda bambina, cè il mare mosso, bandiera rossa...bandiera rossa.." ORA VORREI TANTO... ORA VORREI TANTO... ORA VORREI TANTO... PARANOIE Nessuna scelta effettuata MERAVIGLIE Nessuna scelta effettuata BLOG che SEGUO: MUTTER siriasun MORTIIS misia companera norin *hide* tatasux Jackie punkle crystal83 Rockhaya chiachiara jslf pisolina temporale baji dramaqueen chickfit daisychain Beatrix_K violante twilight crusca uèuè rimini Chiara@ leccezione alla regola: squalonoir grazie a lui sono ateo: di0 Lopposizione degli opposti: odum mi sta simpatico perchè gli sto sulle balle: Vitto Grezzo ma pur sempre un diamante: Ademarki ti prego...calmati!! Anfratto Capitalista Bolscevico: m.organ sò communista cosììììììììì!!! tonymanero BOOKMARKS Il morto del mese (da Tempo Libero / Bellezza ) Report (da Informazione / Agenzie di Stampa ) Daniele Luttazzi (blog) (da Informazione / Notizie del Giorno ) Beppe Grillo (da Informazione / Notizie del Giorno ) Corriere Della Sera (da Informazione / Quotidiani ) UTENTI ONLINE: |
"ci sedemmo dalla parte del torto poichè tutti gli altri posti erano occupati" B. Brecht Se cè una definizione che mi è del tutto estranea è "amico di tutti". Ho il mio carattere, ed è probabile, anzi, sicuro che non piaccia a tutti. Pazienza. RINGRAZIAMENTI: Ringrazio tutti coloro che frequentano il mio blog con frequenza e regolarità, nonostante io non abbia con loro alcun tipo di rapporto di amicizia, parentela o semplice conoscenza. Non preoccupatevi. So che siete timidi. venerdì 23 marzo 2007 - ore 08:11 - scomode situazioni contingenti -  LEGGI I COMMENTI (3) - PERMALINK giovedì 22 marzo 2007 - ore 13:37 - Ritratto d’un millantatore -  LEGGI I COMMENTI (3) - PERMALINK giovedì 22 marzo 2007 - ore 11:45 - "Invecchiando sei diventato più saggio?" - ...Francamente, mi sento un pò come quei cachi colti troppo presto, che passano direttamente dallesser crudi allesser marci. LEGGI I COMMENTI (2) - PERMALINK giovedì 22 marzo 2007 - ore 08:18 - Aprile dolce Dormire -  COMMENTA (0 commenti presenti) - PERMALINK mercoledì 21 marzo 2007 - ore 14:24 - catastrofiche alchimie -  COMMENTA (0 commenti presenti) - PERMALINK mercoledì 21 marzo 2007 - ore 13:33 - Crisi nei Rapporti, Crisi dei Trasporti -  COMMENTA (0 commenti presenti) - PERMALINK mercoledì 21 marzo 2007 - ore 11:58 - "...perchè la lontananza è l’unica vendetta, è l’unico perdono.. " -  COMMENTA (0 commenti presenti) - PERMALINK mercoledì 21 marzo 2007 - ore 08:20 - l’Illogicità della chimica interpersonale - COMMENTA (0 commenti presenti) - PERMALINK martedì 20 marzo 2007 - ore 15:55 - Il teorema del Distacco -  COMMENTA (0 commenti presenti) - PERMALINK martedì 20 marzo 2007 - ore 11:37 - Riflessione sull’animo umano - E’ incredibile come, nonostante io non sia più un ragazzino, le persone riescano sempre a stupirmi. La cosa desolante è ciò che suscita il mio stupore raramente ha connotazioni positive. LEGGI I COMMENTI (1) - PERMALINK > > > MESSAGGI PRECEDENTI |
|||